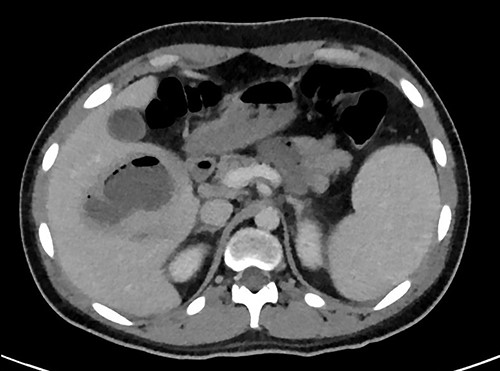
Transverse plane of the CT showing the hepatic collection measuring 8 × 5 cm.

-
PDF
- Split View
-
Views
-
Cite
Cite
Ayman Bsat, Karim Ataya, Bassam Osman, Basel Hafez, Dana Kanafani, Razan Hallak, Mohamad Jawad Khalife, Indirect ballistic injury to the liver resulting in retained bullet complicated with hepatic abscess: a case report, Journal of Surgical Case Reports, Volume 2022, Issue 7, July 2022, rjac261, https://doi.org/10.1093/jscr/rjac261
Close - Share Icon Share
Abstract
Indirect and extraperitoneal penetrating liver injury is an extremely uncommon phenomenon. In this report, we highlight the case of an 18-year-old male patient that sustained a gunshot wound with an entry site through the right buttock and landed in the liver. He presented to us in sepsis due to developing a hepatic abscess at the site of the dislodged bullet that was confirmed with computed tomography. Interestingly, the ballistic missile did not cause any visceral injury due to its indirect and extraperitoneal trajectory. The patient underwent diagnostic laparoscopy, where the hepatic abscess was unroofed and evacuated. A free-floating bullet was found and extracted, and a small bile duct leak was repaired. The patient had an uneventful post-operative course and was duly discharged on an empiric course of antibiotics.
INTRODUCTION
Retained foreign bodies in the liver secondary to surgery or penetrating trauma is a rather uncommon phenomenon with a paucity of cases recorded in the literature [1]. Even more uncommon are indirect extraperitoneal hepatic injuries from ballistic traumas. Most recorded cases of indirect ballistic injuries involved the small bowel, colon and spleen [2]. In this article, we present the case of an indirect hepatic injury via a high-velocity ballistic missile resulting in a dislodged bullet in the liver complicated with a hepatic abscess.
CASE REPORT
An 18 year old previously healthy man presented to the emergency department with a two-week history of high-grade fever. History goes back to 16 days ago when the patient was shot with a handheld pistol at close range to the right buttock. The patient was transported to the nearest hospital where he was managed conservatively with pain control and antibiotics due to a lack of expertise and resources in hepatobiliary surgery. After two weeks of antibiotherapy, the patient’s condition did not improve and he presented to the emergency department of our institution with debilitating high-grade fever and a clinical picture of sepsis and impending septic shock. Inspection of the patient revealed the presence of a wound in the right superior posterior gluteal region, the entry site of the bullet, with no exit wound (Fig. 1). On physical exam, the patient had a soft, non-peritonitic and non-distended abdomen with slight tenderness to palpation on the right upper quadrant.
A full lab panel was ordered and revealed a total bilirubin of 1.1, direct bilirubin 0.5, lactate dehydrogenase 196, alkaline phosphatase 80, aspartate transaminase 46 and alanine transaminase 58. A computed tomography (CT) angiographic scan of the chest, abdomen and pelvis revealed the presence of a rim enhancing fluid collection in hepatic segment V with internal gas and containing a metallic foreign body, measuring 8 × 5 cm and consistent with abscess formation (Figs 2–4). The linear tract of the bullet in the right iliac crest was visualized in the CT as well.

Entry site of the bullet in the superior–posterior aspect of the right gluteal region.
Transverse plane of the CT showing the hepatic collection measuring 8 × 5 cm.

Transverse plan of the CT showed the bullet lodged in segment 5 of the liver.

Coronal plane of CT showing the retained bullet and hepatic abscess.
The patient was admitted to the hepatobiliary service and underwent a diagnostic laparoscopy, which revealed the location of the hepatic abscess to be in segment 6 of the liver (Fig. 5). The abscess was unroofed and evacuated, revealing a free-floating bullet that was promptly extracted (Fig. 6). Further exploration of the cavity after evacuation of the abscess revealed a small duct leaking bile, which was sutured and clipped.


The patient had an uneventful post-operative course, during which he received piperacillin–tazobactam empirically. Intra-operative cultures returned negative, so the patient was discharged home on an intra-abdominal drain and an empiric course of metronidazole and ciprofloxacin.
DISCUSSION
This report presents a rare case of an indirect liver injury in the form of a retained bullet resulting in a liver abscess. More interestingly is the indirect route of the bullet, as its initial entry point was in the right gluteal region, resulting in an indirect and extraperitoneal entry into the liver. This is a highly unusual mechanism of foreign body implantation into the liver. Hepatic abscess development as a complication of retained foreign object is also a rare phenomenon, with less than 100 cases reported in the literature that were mostly caused by the inadvertent ingestion of fishbone [3].
Retained foreign objects in the liver complicated with hepatic abscess formation tend to be asymptomatic or have non-specific symptoms, such as right upper quadrant abdominal pain, fever, anorexia and weight loss [4]. In this case, the patient reported only mild abdominal discomfort and only referred to our center after he remained febrile despite receiving antibiotherapy. Unlike cryptogenic liver abscesses that tend to occur in the right hepatic lobe, abscess due to retained foreign bodies occur more commonly in the left hepatic lobe [5].
The management of retained foreign bodies in the liver remains controversial [6]. CT scan with contrast is generally considered the diagnostic imaging of choice for the study and assessment of retained hepatic foreign bodies [7]. However, the detection of the foreign body via CT scan can be technically challenging and can be easily misinterpreted as an ‘artifact’ without high enough clinical suspicion [8, 9]. In their systematic review published in 2010, the foreign body was detected in only 2/27 (7.47%) CT scans performed for patients presenting with liver abscess due to retained foreign body. Diagnostic laparoscopy or laparotomy, on the other hand, had a 76% detection rate for retained foreign bodies [5].
Liver traumas in hemodynamically unstable patients are managed with exploratory laparotomy with the primary intention of controlling liver bleeding and preventing exsanguination. On the other hand, hemodynamically stable liver injuries are managed conservatively and expectantly. Liver abscess management depends primarily on the etiology and size of the abscess, with surgical interventions being delegated to the most severe cases only due to being associated with a high mortality rate [10]. However, medical management of foreign-body associated hepatic abscesses have an unacceptably low success rate of only 9.5% if the foreign body is not removed [5]. Foreign body removal is, thus, imperative for successful treatment of this condition and can be performed via a variety of modalities, including open surgery, laparoscopic approach, endoscopy and via percutaneous interventional techniques, with surgery (open and laparoscopic) being the most utilized treatment modality [7, 10–14].
CONCLUSION
Retained foreign body in the liver is an uncommon phenomenon, even less so when it is due to an indirect ballistic missile. In this case report, we highlight a rather rare presentation of indirect hepatic injury resulting in a dislodged foreign body within the liver complicated with a perihepatic abscess. It is important to be wary of indirect injuries resulting from ballistic missiles. Imaging of the patient is vital to localize the location of the foreign body, characterize the damage caused by it and plan for optimal treatment. Foreign bodies retained in the liver respond poorly to medical management and will almost always need endoscopic or surgical intervention. Traditionally, exploratory laparotomy has been the technique of choice. However, laparoscopic, endoscopic and percutaneous techniques have emerged as viable alternatives with less morbidity.
CONFLICT OF INTEREST STATEMENT
The authors testify that they have no conflicts of interest to declare.
FUNDING
The authors received no financial support for the research, authorship, and/or publication of this article.